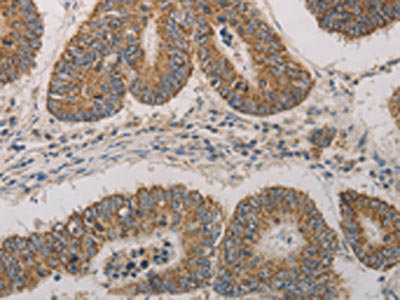

-
中文名稱:CDKN1A兔多克隆抗體
-
貨號:CSB-PA297162
-
規格:¥1100
-
圖片:
-
The image on the left is immunohistochemistry of paraffin-embedded Human colon cancer tissue using CSB-PA297162(CDKN1A Antibody) at dilution 1/20, on the right is treated with fusion protein. (Original magnification: ×200)
-
Gel: 10+12%SDS-PAGE, Lysate: 40 μg, Lane: Human liver cancer tissue, Primary antibody: CSB-PA297162(CDKN1A Antibody) at dilution 1/300, Secondary antibody: Goat anti rabbit IgG at 1/8000 dilution, Exposure time: 30 seconds
-
-
其他:
產品詳情
-
Uniprot No.:
-
基因名:
-
別名:CAP20 antibody; CDK-interacting protein 1 antibody; CDKI antibody; CDKN1 antibody; Cdkn1a antibody; CDN1A_HUMAN antibody; CIP1 antibody; Cyclin Dependent Kinase Inhibitor 1A antibody; Cyclin-dependent kinase inhibitor 1 antibody; Cyclin-dependent kinase inhibitor 1A (P21) antibody; Cyclin-dependent kinase inhibitor 1A (p21, Cip1) antibody; DNA Synthesis Inhibitor antibody; MDA-6 antibody; MDA6 antibody; Melanoma differentiation-associated protein 6 antibody; Melanoma differentiation-associated protein antibody; p21 antibody; P21 protein antibody; p21CIP1 antibody; p21Cip1/Waf1 antibody; p21WAF antibody; PIC1 antibody; SDI1 antibody; SLC12A9 antibody; WAF1 antibody; Wild type p53 activated fragment 1 (WAF1) antibody; Wild type p53 activated fragment 1 antibody; Wildtype p53-activated fragment 1 antibody
-
宿主:Rabbit
-
反應種屬:Human
-
免疫原:Fusion protein of Human CDKN1A
-
免疫原種屬:Homo sapiens (Human)
-
標記方式:Non-conjugated
-
抗體亞型:IgG
-
純化方式:Antigen affinity purification
-
濃度:It differs from different batches. Please contact us to confirm it.
-
保存緩沖液:-20°C, pH7.4 PBS, 0.05% NaN3, 40% Glycerol
-
產品提供形式:Liquid
-
應用范圍:ELISA,WB,IHC
-
推薦稀釋比:
Application Recommended Dilution ELISA 1:1000-1:5000 WB 1:200-1:1000 IHC 1:25-1:100 -
Protocols:
-
儲存條件:Upon receipt, store at -20°C or -80°C. Avoid repeated freeze.
-
貨期:Basically, we can dispatch the products out in 1-3 working days after receiving your orders. Delivery time maybe differs from different purchasing way or location, please kindly consult your local distributors for specific delivery time.
-
用途:For Research Use Only. Not for use in diagnostic or therapeutic procedures.
相關產品
靶點詳情
-
功能:May be involved in p53/TP53 mediated inhibition of cellular proliferation in response to DNA damage. Binds to and inhibits cyclin-dependent kinase activity, preventing phosphorylation of critical cyclin-dependent kinase substrates and blocking cell cycle progression. Functions in the nuclear localization and assembly of cyclin D-CDK4 complex and promotes its kinase activity towards RB1. At higher stoichiometric ratios, inhibits the kinase activity of the cyclin D-CDK4 complex. Inhibits DNA synthesis by DNA polymerase delta by competing with POLD3 for PCNA binding. Plays an important role in controlling cell cycle progression and DNA damage-induced G2 arrest.
-
基因功能參考文獻:
- eIF2alpha-P is cytoprotective in response to UVB by a mechanism featuring translation of a specific splice variant of CDKN1A that facilitates G1 arrest and subsequent DNA repair. PMID: 29118075
- No significant differences were found in the frequency of alleles of CDKN1A gene in the group of healthy children and children with Down syndrome and dental caries. PMID: 29578436
- In vitro studies in human lung fibroblasts revealed increased levels of p21 (p = 0.0032) and pAkt (p = 0.12) following treatment with serotonin. PMID: 29386571
- Data suggest that CRNDE may function as an oncogene by modulating p21, finally contributing to the radioresistant phenotype formation of LAD cells. PMID: 28550688
- Cyclin dependent kinase inhibitor 1A (p21) expressions is upregulated in non-cycling HCT116 p53(+/+) cells and HIV-1 reverse transcription is subsequently inhibited. The restrictions of HIV by p21 is associated with the suppression of ribonucleotide reductase R2 subunit expression and phosphorylation of SAMHD1 protein. siRNA knockdown of p21 increased HIV-2 infection in human monocyte derived macrophages. PMID: 29587790
- Data indicate how cyclin dependent kinase inhibitor 1A (p21) regulates the proliferation-quiescence decision to maintain genomic stability. PMID: 28317845
- The first evidence for non-repair functions of MGMT in cell cycle and highlight the involvement of PCNA in MGMT downregulation, with p21 attenuating the process. PMID: 29510343
- Scriptaid was also able to dose dependently and significantly induce MM cell cycle arrest at the G2/M phase. PMID: 29305109
- High CDKN1A expression is associated with migration, invasion, and progression of bladder cancer. PMID: 29602637
- CDKN1A role in DANCR-mediated tumor cell growth. PMID: 29180471
- CDKN1A expression was seen only in five cases and that too focally in the cytoplasm, thereby warranting removal of analysis of CDKN1A positivity from the study PMID: 29893337
- Results show that knockdown of GABPB1 in clear cell renal cell carcinoma cell lines significantly decreased the ability to form colonies by inducing the expression of p21Waf/Cip1. PMID: 29845229
- Authors demonstrate that HMGB2 transcription is repressed by p21 during radiation-induced senescence through the ATM-p53-p21 DNA damage signaling cascade. The loss of p21 abolished the downregulation of HMGB2 caused by ionizing radiation, and the conditional induction of p21 was sufficient to repress the transcription of HMGB2. PMID: 29487276
- Low CDKN1A expression is associated with cervical cancer. PMID: 30098344
- p21 was involved in glioma cell proliferation after SNHG6 was downregulated. PMID: 29579705
- the CDK inhibitor p21 begins rising in G2 in mother cells whose daughters exit mitosis into the pre-Restriction Point, CDK2(low) state. Furthermore, degradation of p21 coincides with escape from the CDK2(low) state and passage through the Restriction Point. PMID: 30111539
- SAC decreased the levels of 5-methylcytosine, DNMT activity, messenger RNA (mRNA) and protein levels of DNMT1. Additionally, SAC treatment resulted in re-expression of the mRNA and proteins of silenced tumor suppressor gene CDKN1A accompany with reduced cell division control 2 expression. PMID: 29759079
- Down-regulation of HOTAIR elicits an inhibitory effect on proliferation, invasion, and migration, while promoting the apoptosis of colorectal cancer cells through the up-regulation of p21. PMID: 29808247
- Glutaredoxin-1 silencing induces cell senescence via p53/p21/p16 signaling axis. PMID: 29356545
- p16, p21, and p53 proteins play an important role in the deregulation of the cell cycle and participate in the development of pancreatic intraepithelial neoplasia. PMID: 29388054
- Here, the authors demonstrated that CUL4B forms an E3 ligase with RBX1 (RING-box 1), DDB1 (DNA damage binding protein 1), and DCAF11 (DDB1 and CUL4 associated factor 11) that promotes the ubiquitination of p21(Cip1) and regulates cell cycle progression in human osteosarcoma cells. PMID: 28446751
- Low CIP1 expression is associated with gastric cancer. PMID: 30031062
- PAK1 is upregulated in cutaneous T cell lymphoma. PAK1 silencing induced apoptosis and inhibited cell growth by stimulating the expression of PUMA and p21. PMID: 29307600
- These findings reveal an important mechanism by which p21 can be stabilized by direct deubiquitylation, and they pinpoint a crucial role of the USP11-p21 axis in regulating cell-cycle progression and DNA damage responses. PMID: 29666278
- Polymorphisms in TP53 and P21 proteins are associated with an increased risk of stomach cancer. PMID: 29124536
- A chimeric cDNA construct of human p53 was made where the 1-260 bp N-terminus was replaced with buffalo p53 counterpart and expressed in H1299 cell line. The tetramerization ability of the chimeric p53 protein was comparable to that of h-p53. Properties of b-p53 like stronger p21 transactivation and super sensitivity to Mdm2 mediated degradation were lacking in the chimeric protein. PMID: 29147811
- The associated effects appear to be mediated by inhibition of IGFBP-2 expression and stimulation of p21 expression. This suggests that simulated microgravity might represent a promising method to discover new targets for glioma therapeutic strategy. PMID: 28707224
- variants of EGFR and SYNE2 play an important role in p21 regulation and are associated with the clinical outcome of HBV-related hepatocellular carcinoma in a TP53-indenpdent manner PMID: 27502069
- GRh2 dose-dependently inhibited prostate cancer cell proliferation, but did not alter cell apoptosis, seemingly through downregulation of miR-4295, which inhibits protein translation of CDKN1A. PMID: 29457293
- These results demonstrate that miR-95-3p is a potential new marker for Hepatocellular carcinoma and regulates hepatocarcinogenesis by directly targeting CDKN1A/p21 expression. PMID: 27698442
- rescue experiments indicated that SNHG20 functioned as an oncogene partly via repressing p21 in non-small cell lung cancer (NSCLC) cells. Taken together, our findings demonstrate that SNHG20 is a new candidate for use in NSCLC diagnosis, prognosis and therapy. PMID: 28981099
- Expression of CIP/KIP proteins was found abundantly within the proliferative hair matrix, concomitant with a role in cell cycle checkpoint control. p21(CIP1), p27(KIP1) and cyclin E persisted within post-mitotic keratinocytes of the pre-cortex, whereas p57(KIP2) protein decreased but became nuclear. PMID: 28413121
- AIbZIP induced by the androgen receptor axis plays a crucial role in the p21 dependent proliferation of androgen-sensitive prostate cancer cells. PMID: 27853318
- both the p53-Puma/Noxa/Bax pathway and the cell cycle arrest-associated p53-p21 pathway were involved in the AZT-induced cell cycle arrest (p53-p21) and DNA double-strand breaks (gamma-H2AX), while euploid cells were more sensitive to AZT-induced apoptosis (p53-Puma/Bax/Noxa). PMID: 28627647
- The transcriptional regulation of the p21 promoter by iron chelators was demonstrated to be dependent on the chelator and cell-type examined.A 50-bp region between -104 and -56-bp was required for Dp44mT-induced activation in SK-MEL-28 cells. It had several Sp1-binding sites. The Sp1-3-binding site played a significant role in Dp44mT-induced p21 activation. Dp44mT increased the interactions of Sp1 and ERalpha and c-jun. PMID: 29032246
- serpinB2 bound to and stabilized p21 to mediate senescence in a proteasome-independent manner, indicating that serpinB2 has a direct role in senescence. Thus, this study reveals a unique mechanism by which serpinB2 maintains senescence through stabilization of p21 protein levels. PMID: 28794016
- cMyc promotes rhabdomyosarcoma development by inhibiting apoptosis through repression of p21 transcription. PMID: 28765944
- The results suggest that p53 simultaneously controls multiple pathways to induce cellular senescence through p21 and Akt. PMID: 28691365
- Data show that cortactin-mediated p21Cip1 nuclear export and degradation facilitating MCP1-induced human aortic smooth muscle cell (HASMC) proliferation. PMID: 27363897
- Low P21 expression is associated with clear cell and endometrioid carcinoma of the ovary and the endometrium. PMID: 29451900
- PAK4 downregulated the level of p21 and enhanced the activity of Akt as well. And we conclude that PAK4 acts as a regulator of cell cycle progression of vascular smooth muscle cells by mediating Akt signaling and controlling p21 levels, which further modulate intimal hyperplasia and vascular smooth muscle cells proliferation PMID: 28706947
- CBX3 promotes tumor proliferation by regulating G1/S phase via p21 downregulation and associates with poor prognosis in tongue squamous cell carcinoma PMID: 29462646
- The results presented herein highlight the importance of p21Cip1 and p27Kip1 in the cell cycle control and drug resistance of glioma stem cells, providing new insights into the field of glioma biology. PMID: 28582703
- LncRNA-ANCR inhibited the cell proliferation, migration, and invasion of osteosarcoma cells, possibly through interacting with EZH2 and regulating the expression of p21 and p27. PMID: 28679390
- p21 is a bona fide ubiquitylation substrate for CHIP.p21 role in lung cancer radioresistance. PMID: 28232384
- PVT1 played a pivotal part on the regulation of p21 expression in breast cancer cell lines. PMID: 28534994
- Thus, the present study indicated that parkin knockout inhibits neural stem cell differentiation by JNK-dependent proteasomal degradation of p21. PMID: 28656059
- Our findings show that the overexpression of p21;{Waf1/Cip1}, down-expression of p57;{Kip2} and gene promoter methylation of p57;Kip2 could be considered as promising diagnostic markers for breast cancer PMID: 28106536
- PKCzeta was specifically involved in ACOT7 depletion-mediated cell cycle arrest as an upstream molecule of the p53-p21 signaling pathway in MCF7 human breast carcinoma and A549 human lung carcinoma cells. PMID: 28518146
- HNF1A-AS1 promoted HCC cell proliferation by repressing the NKD1 and p21 expression. PMID: 28292020
顯示更多
收起更多
-
亞細胞定位:Cytoplasm. Nucleus.
-
蛋白家族:CDI family
-
組織特異性:Expressed in all adult tissues, with 5-fold lower levels observed in the brain.
-
數據庫鏈接:
Most popular with customers
-
-
YWHAB Recombinant Monoclonal Antibody
Applications: ELISA, WB, IHC, IF, FC
Species Reactivity: Human, Mouse, Rat
-
Phospho-YAP1 (S127) Recombinant Monoclonal Antibody
Applications: ELISA, WB, IHC
Species Reactivity: Human
-
-
-
-
-